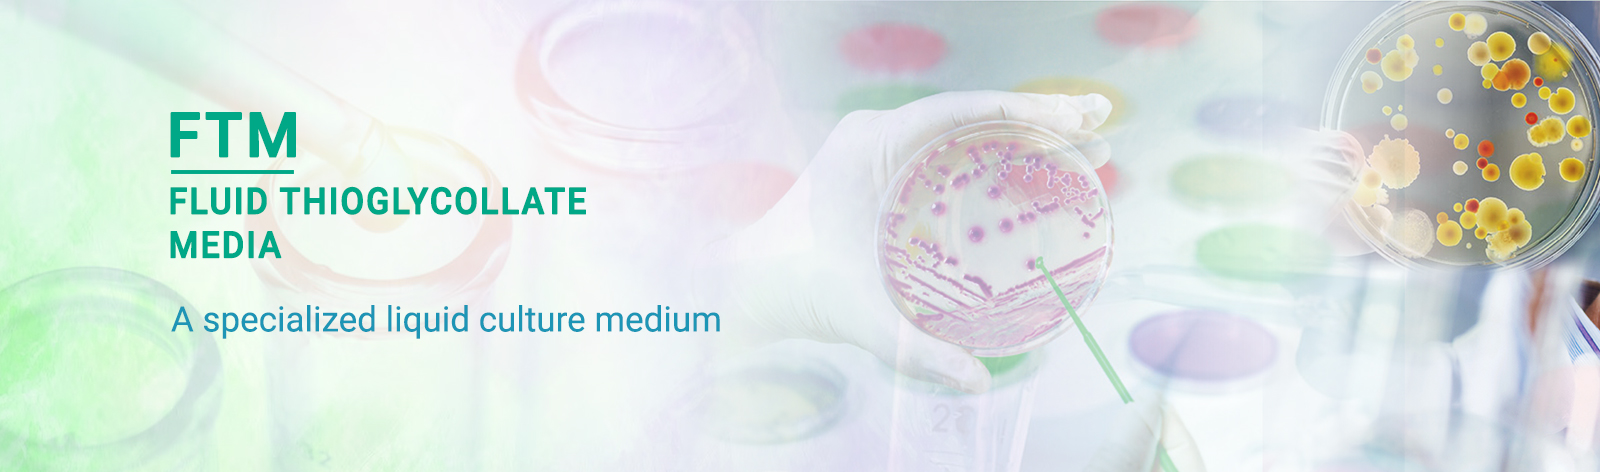

Essential Guide to Routine Testing for Legionella in 2026
Post Date:
23Jan, 2026
Legionella outbreaks are on the rise, posing serious risk to public health across hospitals, hotels, office buildings, and other water systems. According to the CDC, the number of reported Legionnaires’ disease cases in the U.S. has nearly tripled since the early 2000s, and global trends suggest a similar upward trajectory.
Mastering MacConkey Agar: A Comprehensive Guide for Researchers and Clinicians in 2026
Post Date:
23Jan, 2026
Accurate bacterial identification often marks the line between timely intervention and delayed diagnosis. In the fast-paced environment of a clinical microbiology laboratory, a single Petri dish can influence critical decisions—from selecting the appropriate antibiotic to determining the speed of patient recovery or identifying the early signs of an outbreak.
Guide to Pharmaceutical Testing Culture Media
Post Date:
22Jan, 2026
Microbiological testing constitutes a critical element of pharmaceutical quality control systems and plays a fundamental role in ensuring that drug products meet established safety, quality, and regulatory requirements prior to their market release.
Deoxycholate Agar: A Selective and Differential Medium for Enteric Pathogen Detection
Post Date:
21Jan, 2026
Deoxycholate Agar is a selective and differential culture medium commonly used in microbiological laboratories for the isolation and differentiation of enteric Gram-negative bacteria, particularly members of the family Enterobacteriaceae, with specific emphasis on the detection of Salmonella and Shigella species.
Fluid Thioglycollate Medium (FTM): A Versatile Medium for Aerobic, Anaerobic, and Fastidious Microorganism Detection
Post Date:
20Jan, 2026
Fluid Thioglycollate Medium (FTM) is a highly versatile, enriched, and reducing medium designed for the cultivation, propagation, and detection of both aerobic and anaerobic microorganisms. Widely used in clinical, pharmaceutical, and industrial laboratories, FTM is particularly essential for sterility testing, microbial quality control, and studies involving fastidious or oxygen-sensitive organisms.
Fluid Thioglycollate Medium (FTM): Types and Applications
Post Date:
19Jan, 2026
Fluid Thioglycollate Medium (FTM) is a specialized liquid culture medium specifically developed to recover a broad spectrum of microorganisms in environments with variable oxygen availability. Unlike standard nutrient broths, which are designed primarily for aerobic organisms, FTM incorporates reducing agents such as sodium thioglycollate and L-cystine.
Sterility Testing Media: USP <71> Compliance Overview
Post Date:
16Jan, 2026
Sterility assurance is a critical element of pharmaceutical product quality and patient safety, particularly for parenteral drugs, ophthalmic preparations, biologics, and implantable dosage forms that bypass the body’s natural defense mechanisms. Products intended to be sterile are manufactured using aseptic processing or terminal sterilization, supported by validated manufacturing processes, controlled environments, and comprehensive contamination control strategies.
Compliances of IVD to IVDR and Indian MDR standards
Post Date:
01May, 2024
HiMedia's constant commitment to ensure high standards of safety, quality and performance of in-vitro diagnostic products for use in the health care sector contributes directly and indirectly to the well being of patients across the country and world-wide.